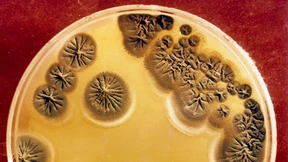
Das globale Antibiotika-Desaster

Ebola hat den Senegal erreicht
Die Zahl der Ebola-Fälle steigt so schnell wie nie zuvor. Und die Epidemie greift auf immer mehr Länder über: Nun gibt es auch im Senegal den ersten bestätigten Fall. Frankreich will die Seuche indes zum Thema des EU-Gipfels machen.